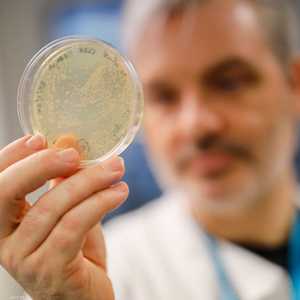
بريطانيا سجلت تسع إصابات حتى الآن

وزير الخزانة الأميركي يكشف آثار كورونا على الاقتصاد
07:45 - 13 فبراير 2020
قال وزير الخزانة الأميركي ستيفن منوتشين، الأربعاء، إن الآثار الاقتصادية السلبية الناتجة عن تفشي فيروس كورونا لن تستمر إلى ما بعد عام 2020.
وأبلغ منوتشين اللجنة المصرفية بمجلس الشيوخ أن فيروس كورونا لن يؤثر على التوقعات الطويلة الأجل لإدارة ترامب لنمو الاقتصاد الأميركي.
وأضاف المسؤول الأميركي: "لا أتوقع أن فيروس كورونا سيكون له تأثير يستمر إلى ما بعد هذا العام".
وأشار إلى أن هناك حاجة إلى ثلاثة أو أربعة أسابيع إضافية من البيانات لتقدير مجمل تأثير فيروس كورونا في الصين.